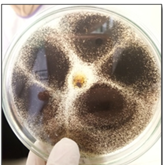

Analis kesehatan adalah salah satu profesi kesehatan yang yang melaksanakan pelayanan pemeriksaan, pengukuran, penetapan, dan pengujian terhadap bahan yang berasal dari manusia atau bahan bukan berasal dari manusia untuk penentuan jenis penyakit, penyebab penyakit, kondisi kesehatan atau faktor-faktor yang dapat berpengaruh pada kesehatan perorangan dan masyarakat. Oleh karena itu secara umum analis kesehatan adalah salah satu profesi kesehatan yang bekerja di sebuah laboraroium kesehatan.
Apa
bedanya analis kesehatan dengan Ahli Teknologi Laboratorium Medik?
Ahli
Teknologi Laboratorium Medik merupakan nama lain dari analis kesehatan, yakni
salah satu profesi kesehatan yang bekerja dan bertanggungjawab di laboratorium.
Menurut KEPMENKES RI NOMOR 370/MENKES/SK/III/200, Analis Kesehatan atau disebut
juga Ahli Teknologi Laboratorium Kesehatan adalah tenaga kesehatan dan ilmuan
berketerampilan tinggi yang melaksanakan dan mengevaluasi prosedur laboratorium
dengan memanfaatkan berbagai sumber daya.
Apa aja sih yang dipelajari di analis kesehatan?
Analis kesehatan memiliki cakupan pemeriksaan yang luas antara lain pemeriksaan mikrobiologi (bakteri), parasitologi (fungi, protozoa, cacing), hematologi (sel-sel darah serta plasma), imunologi (antigen, antibodi), kimia klinik (hormon, enzim, glukosa, lipid, protein, elektrolit, dll), toksikologi klinik, virology (virus) dll. Sarana kesehatanuntuk analis kesehatan berbentuk Laboratorium Kesehatan seperti Laboratorium Patologi Klinik dan Laboratorium Patologi Anatomi. Laboratorium Patologi Klinik yang memeriksa sampel berupa cairan2 tubuh manusia seperti darah, sputum, faeces, urine, liquor cerebro spinalis (cairan otak), dan lain-lain untuk mendapatkan data atau hasil sebagai penegakan diagnosa terhadap suatu penyakit. Sedangkan untuk Laboratorium Patologi Anatomi seorang analis bertugas untuk membuat sediaan preparat dari sampel bagian organ tubuh (biasanya yang diambil setelah operasi) kemudian dibaca oleh seorang dokter.
Kerjaan analis kesehatan ngapain aja sih?
Jika kalian pernah pergi ke rumah sakit atau
fasilitas pelayanan kesehatan lainnya, kadang kalian disuruh dokter untuk check
laboratorium diambil darahnya atau disuruh kencing, dll. Nantinya darah atau
air kencing
kalian ditaruh di suatu tempat untuk dikirim ke laboratorium untuk diperiksa.
Nah disini tugas seorang analis kesehatan untuk memeriksa.
Ambil
darah? Bukannya seorang perawat juga bisa?
mungkin
perawat, dokter, bahkan ahli kesehatan lain bisa, tetapi analislah yang
terlatih dan mempunyai kewenangan bahkan sertifikat untuk memeriksa yang
demikian. Walaupun yang berhak menyimpulkan hasil akhir adalah dokter.
Bukannya yang memeriksa itu adalah tugas seorang
dokter ya?
Memang yang memeriksa adalah seorang dokter, tetapi biasanya seseorang setelah diperiksa diberi kertas hasil pemeriksaan, nah kertas hasil pemeriksaan itu dari laboratorium, yang memeriksa dan menulis hasil tersebut adalah seorang analis kesehatan. Oleh karena itu salah satu tugas seorang analis kesehatan adalah membantu dokter dalam mendiagnosa suatu penyakit. Makannya kerjaan analis cuma di balik layar karena tidak bertemu secara langsung dengan pasien tapi fungsi analis kesehatan sangat penting. Sebuah pekerjaan yang beresiko tinggi. Harus teliti, dan berhati-hati. Karena selain hasil yang harus dipertanggungjawabkan kita juga berhadapan dengan spesimen yang bisa saja menularkan penyakit. Mulai dari penyakit ringan sampai yang fatal seperti hepatitis dan HIV.
sumber : http://wawahyuas.blogspot.com/search/label/Analis%20Kesehatan